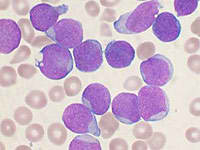

Definició

La leucèmia és un càncer de la sang que afecta cada any al voltant de 5.000 persones en Espanya. La leucèmia és el càncer de les cèl·lules sanguines, normalment dels glòbuls blancs. És el tipus més comú en els nens i joves. Les cèl·lules sanguínies ens formes en la medul·la óssa. Els glòbuls blancs ajuden a l'organisme a combatre les infeccions. Però, en les persones amb leucèmia, la medul·la óssa produeix glòbuls blancs diferents.
Aquestes, reemplacen a les cèl·lules sanguínies sanes i dificulten que la sang faci la seva funció.
Hi ha dos tipus de leucèmia: la leucèmia aguda es desenvolupa més rapidament, en canvi la leucèmia crònica creix més lentament.
- Leucèmia mieloide aguda infantil
És condicions normals la medul·la óssa produeix unes cèl·lules denominades mieloblastos que es converteixen en granulòcits, són les cèl·lules encarregades de la defensa de l'organisme contra les infeccions. En la LMA les cèl·lules de la línia mieloide proliferen de forma anorma linvent progressivament la medul·la óssa interferint en la producció de cèl·lules normals de la sang que originen insuficiència medul·la i s'infiltren teixits intramedul·lars.
La incidència de la LMA en la població infantil en el nostre país s'estima en 8 nous casos per milió d'habitants.
- Leucèmia limfoblàstica aguda infantil
Les cèl·lules cancerígens es multipliquen rapidament i es desplacen a les cèl·lules normals de la medul·la óssa, el teixit tou del centre dels ossos on és formen les cèl·lules sanguínies.
En condicions normals els limfòcits es produeixen a la medul·la óssa i en altres òrgans del sistema limfàtic, se'n els encarregats de les nostres defensa al ser capaces d'atacar, directament o través de la producció d'unes substàncies denominades anticossos, qualsevol cèl·lula anòmala que es produeixi en el nostre organisme.
En la LLA, els limfoblasts es fabriquen en quantitats excessives i no maduren. Aquests limfòcits immadurs envaeixen la sang, la medul·la òssia i els teixits limfàtics, de manera que s'inflamen. També poden envair altres òrgans. La LLA és la forma més comuna de leucèmia infantil i és diagnostiquen uns 30 casos per milió d’habitants i per any, sent així un dels càncers infantil més comú.